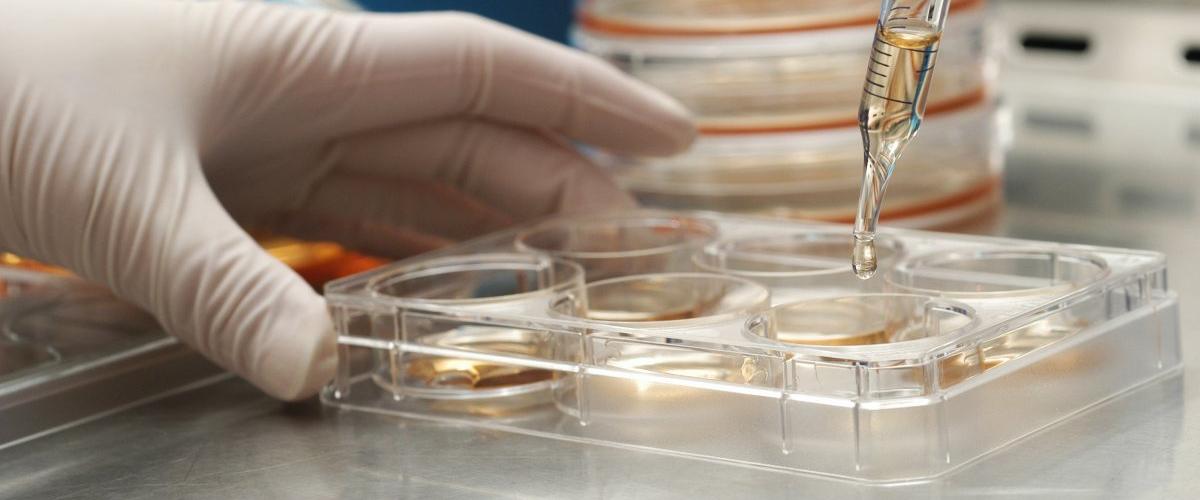
TODO:

Специалисты из Университета Шефилда и Университетского колледжа Лондона идентифицировали с помощью стволовых клеток ключевой этап в формировании энтеральной нервной системы и смогли вырастить энтеральные нервные клетки в лаборатории, пишет Science Daily.
Энтеральная нервная система состоит из 400 — 600 млн нервов и регулирует важные процессы — переваривание пищи, абсорбцию жидкости и коммуникацию с иммунной системой. Сбои в ее работе часто связаны с опасными для жизни расстройствами, такими как болезнь Гиршпрунга. Есть исследования, которые связывают с энтеральной нервной системой начальную стадию развития болезни Паркинсона.
Результат, которого добилась группа ученых, — это важный первый шаг к выращиванию в лабораторных условиях клеток, которые однажды могут начать применяться в терапевтических целях, в частности, для лечения болезни Гиршпрунга.
«Наше открытие демонстрирует новые пути использования стволовых клеток для лечения ряда заболеваний. Теперь мы планируем использовать эти результаты как основу для лечения и изучения на базе стволовых клеток болезней, вызванных дисфункцией энетеральной нервной системы», — сказал Анестис Цакирдис, глава исследовательской группы.
Механизм превращения идентичных стволовых клеток в различные клетки тканей и органов раскрыли ученые из США. Они проследили этапы всех преобразований в результате действия белка FoxA2, который играет в этом процессе важную роль.